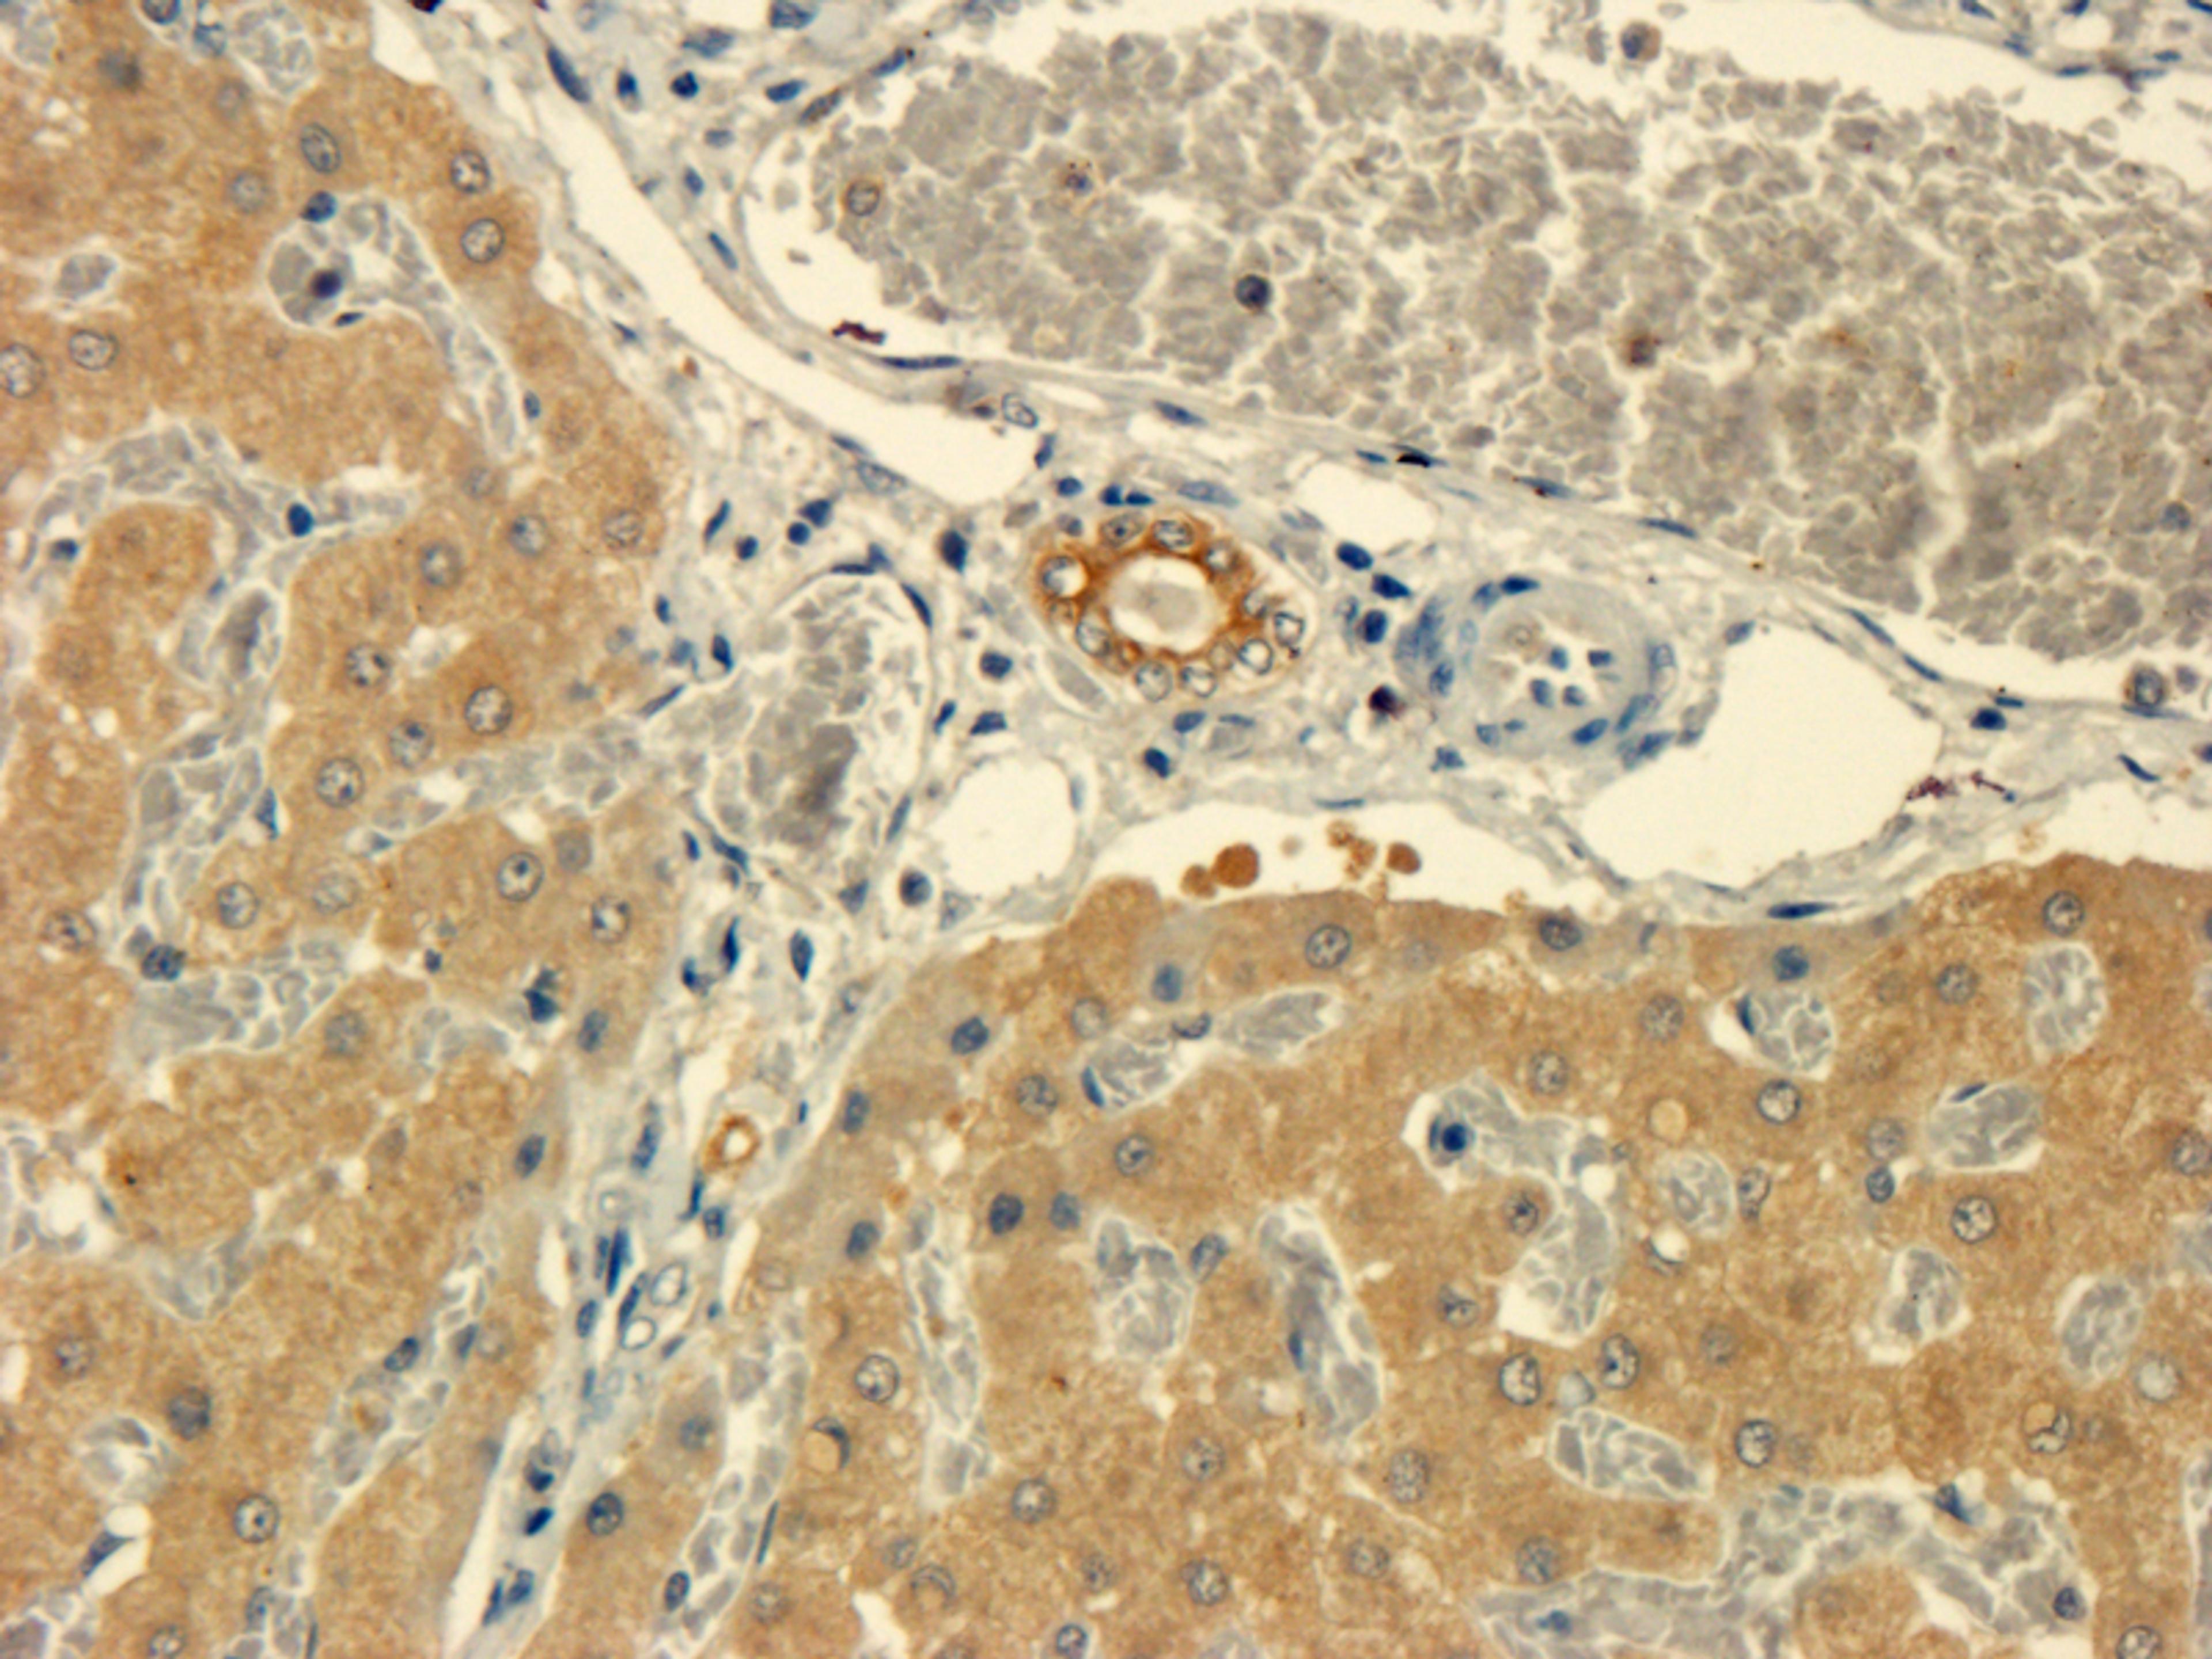
Immunohistochemical staining of pig liver tissue using anti-TNF-alpha (dilution of primary antibody - 1:100)

TNF alpha antibody
Product Details
- Cat. No.
- orb221324
- Type
- Primary Antibody
- Clonality
- Polyclonal
- Host
- Rabbit

The supplier does not provide quotations for this antibody through SelectScience. You can search for similar antibodies in our Antibody Directory.
Description
Rabbit polyclonal to TNF alpha (Tumor Necrosis Factor); which is a protein. Diseases associated with TNF include Migraine with or Without Aura 1 and Asthma. GO annotations related to this gene include identical protein binding and cytokine activity. Cytokine that binds to TNFRSF1A/TNFR1 and TNFRSF1B/TNF. It is mainly secreted by macrophages and can induce cell death of certain tumor cell lines. It is a potent pyrogen causing fever by direct action or by stimulation of interleukin-1 secretion and is implicated in the induction of cachexia; under certain conditions it can stimulate cell proliferation and induce cell differentiation.
Biological Information
- Clonality: Polyclonal
- Host: Rabbit
- Reactivity: Human, Mouse, Rat
- Clone: NULL
- Conjugate: Unconjugated
- Isotype: IgG
- Gene: 7124
Handling
- Quantity: 100 ?g; 200 ?g
- Storage: Store at 4°C for up to two weeks. For long term storage; aliquot and store at -20°C; avoid freeze/thaw cycles.
- Buffer: 10 mM PBS; 0.02% sodium azide
Applications
- ELISA (ELISA)
- Immunohistochemistry (Paraffin-Embedded Sections) (IHC (P))